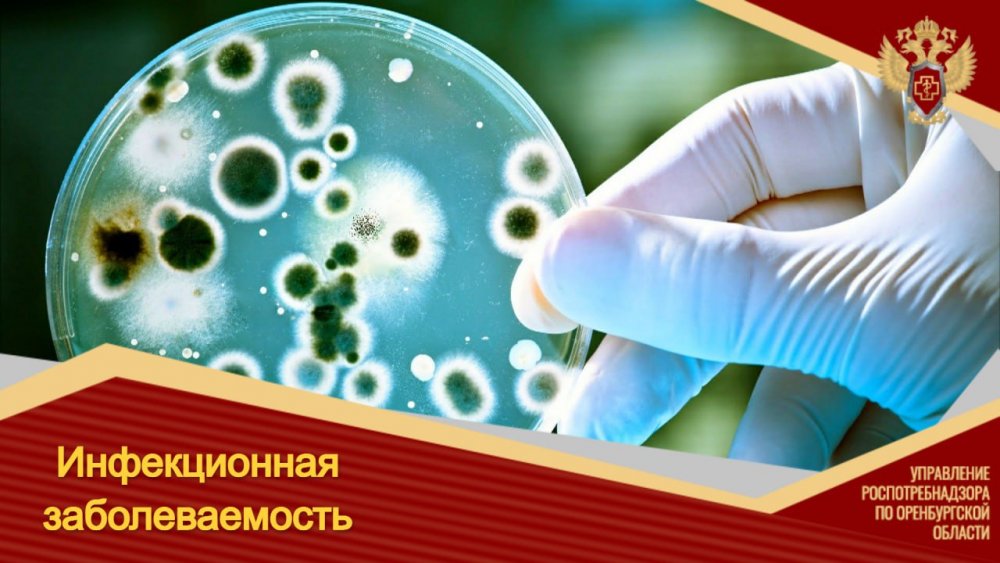

Роспотребнадзор рассказал об эпидемиологической обстановке
Отмечен рост заболеваемости энтеровирусными инфекциями
В региональном управлении Роспотребнадзора рассказали об эпидемиологической обстановке в январе-сентябре 2023 года. За указанный период отмечалось снижение заболеваемости сальмонеллёзом, дизентерией, новой короновирусной инфекцией (COVID-19), педикулезом, чесоткой, гонококковой инфекцией, ВИЧ-инфекцией, лямблиозом, аскаридозом, энтеробиозом, описторхозом.
В управлении отмечают, что не регистрировалась заболеваемость брюшным тифом, острым вирусным гепатитом В, дифтерией, краснухой, эпидемическим паротитом, столбняком, псевдотуберкулезом, тениаринхозом. В виде единичных случаев зафиксирована заболеваемость менингококковой инфекцией, клещевым энцефалитом, болезнью Лайма, острым вирусным гепатитом С.
Отмечен рост заболеваемости энтеровирусными инфекциями, хроническим вирусным гепатитом В, коклюшем, скарлатиной, инфекционным мононуклеозом, токсокарозом.
Фото: Управление Роспотребнадзора по Оренбургской области




Поля, отмеченные *, обязательны для заполнения
Поля, отмеченные *, обязательны для заполнения
Поля, отмеченные *, обязательны для заполнения
Нажимая кнопку "Отправить", вы даете согласие на обработку персональных данных
Поля, отмеченные *, обязательны для заполнения


















